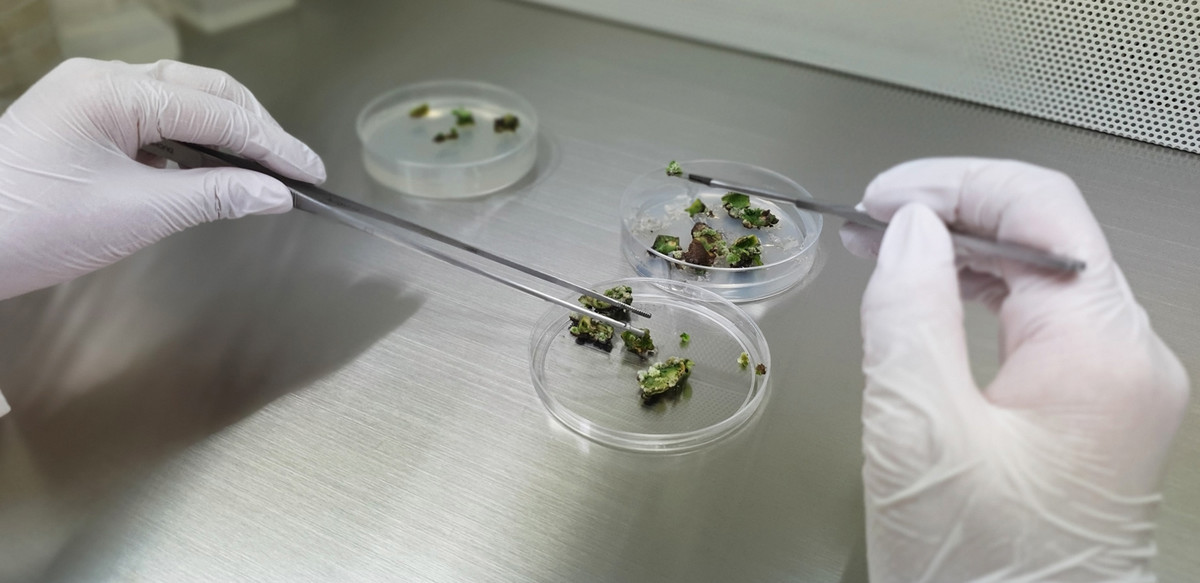

Ολοκληρώθηκε με επιτυχία η Ανάβαση Διονύσου 2021: Θέαμα και συναγωνισμός

 Newsbeast.gr
Newsbeast.gr
Η ιστορική, ταχύτατη Ανάβαση Διονύσου, ολοκληρώθηκε με επιτυχία την Κυριακή 31 Οκτωβρίου, καθώς η απειλούμενη βροχή δεν προέκυψε, παρά μόνο λίγες ψιχάλες που δεν επηρέασαν τη διεξαγωγή του αγώνα. Επίσης, οι αναγκαστικές διακοπές για την αντιμετώπιση περιστατικών, ήταν αρκετά σύντομες ώστε να μην εκτροχιάσουν το πρόγραμμά. Σαν αποτέλεσμα, οι συμμετέχοντες ευχαριστήθηκαν οδήγηση και οι θεατές απόλαυσαν θέαμα. Ας δούμε όμως πώς εξελίχθηκε ο αγώνας ανά κατηγορία. Από τους τρεις οδηγοί του Ενιαίου με ισάριθμα Skoda Fabia ταχύτερος όλο το διήμερο ήταν ο Γ. Σαρταμπάκος, ο οποίος επικράτησε και στα δύο σκέλη της Κυριακής, με καλύτερο χρόνο 2:54.28. Σε απόσταση ασφαλείας πίσω του, ο Κ. Κοφινάς, ση
21:16 01/11/2021